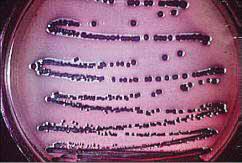

Материал: Микробиология_Лысак, В.В_изд БГУ 2007 -430с
|
|
( 13 |
|
: " Shigella sonnei *# : R # "" |
|||
|
|
|
|
K |
S. sonnei |
|
|
6$$ |
|||
|
|
||
D $ |
– |
d |
|
D$ |
+ |
– |
|
D $ |
– |
d |
|
D $ L-! |
+ |
– |
|
- $-]-D- $# |
+ |
– |
|
|
|
|
|
= ! % : d – 25–75 % 6 !! #$'$* .
$*6 6 !! Shigella # # % , % %$* *> ! - ! % # . $ 1 ! > -# < < 6 !! 6$$, ' 1$ - < < 6 !! .
$* # # ! . P- ! # ! ! 6$$ $ %$. % -– $* $> $. ' #-+ $> . D # # % 6$$ – -$*- $* + -+ (% , # ? # ). D#$> $* > ! (! < , .), #- ? $+ # ? # .
G ! $ + Shigella ! ' % * - $% ; # % + $ $# #$< ' + ! ! ; ! , 6 >? < $*, – + ! , $; ! ( # % >$> $< $+ $% $ 6 % –); # > 1 ( Q ), >? < $* $ # ' % # ' ; -1 , # % >? < > ! .
/ Salmonella % * % . $*! , + - $ $ $+ # ? + , - ? ! Salmonella choleraesuis.
$>% # Salmonella $>? : # ! #$% $! ! (0,7–1,5 2–5! !), $*6$% # ' (# < ), # #$ ! > , > # ! $> ( < $) $ ( -$>% ! S. typhi < < # ), ! >
336